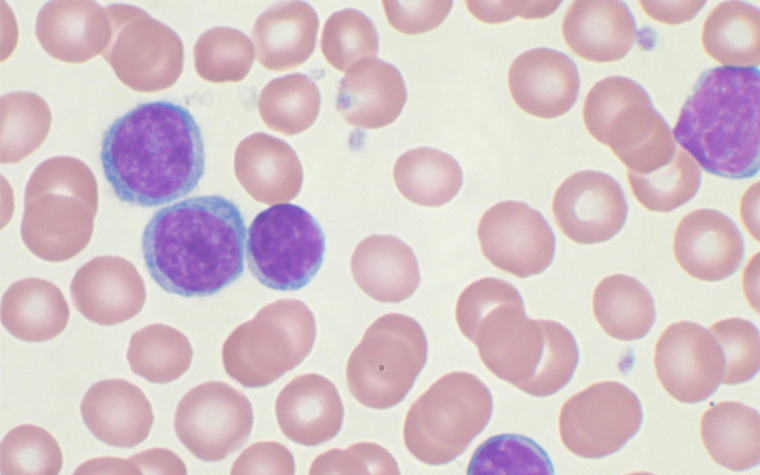

The U.S. Food and Drug Administration (FDA) has granted Breakthrough Therapy Designation to AbbVie’s venetoclax in combination with rituximab, in order to treat lymphocytic leukemia.
This designation allows treatment and therapy candidates to receive priority review placement if the treatments show significant results within preclinical trials. The combined drug candidate would be utilized for relapsed/refractory chronic lymphocytic leukemia (R/R CLL) and was granted this designation after a study that indicated that rituximab was effective in treating the condition.
"This second Breakthrough Therapy Designation for venetoclax granted by the FDA underscores the significant potential of this therapy in treating relapsed/refractory CLL patients and reflects AbbVie's commitment to providing breakthrough therapies for cancer patients," Dr. Michael Severino, chief scientific officer at AbbVie, said. "AbbVie will continue harnessing our collective expertise to accelerate efforts to bring new treatment options to patients battling this difficult to treat blood cancer."
Venetoclax was granted this designation by itself in April of 2015, following preclinical trials indicating its efficacy in treating CL patients that had a deletion gene mutation in 17p.
According to the company, approximately 14,000 people are expected to be diagnosed with this form of leukemia in 2016.